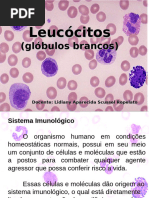

0% acharam este documento útil (0 voto)
61 visualizações20 páginasFisiologia Do Sangue - Leucócitos
O documento aborda a fisiologia do sangue, com foco nos leucócitos, que são as células de defesa do organismo, divididos em polimorfonucleares e mononucleares. Detalha as funções de diferentes tipos de leucócitos, como neutrófilos, eosinófilos, basófilos, monócitos e linfócitos, destacando suas atividades na resposta imune e regulação inflamatória. Além disso, menciona a importância dos linfócitos B, T e células NK na imunidade e vigilância contra infecções e células tumorais.
Enviado por
Talisson BonfimDireitos autorais
© © All Rights Reserved
Levamos muito a sério os direitos de conteúdo. Se você suspeita que este conteúdo é seu, reivindique-o aqui.
Formatos disponíveis
Baixe no formato PDF, TXT ou leia on-line no Scribd
0% acharam este documento útil (0 voto)
61 visualizações20 páginasFisiologia Do Sangue - Leucócitos
O documento aborda a fisiologia do sangue, com foco nos leucócitos, que são as células de defesa do organismo, divididos em polimorfonucleares e mononucleares. Detalha as funções de diferentes tipos de leucócitos, como neutrófilos, eosinófilos, basófilos, monócitos e linfócitos, destacando suas atividades na resposta imune e regulação inflamatória. Além disso, menciona a importância dos linfócitos B, T e células NK na imunidade e vigilância contra infecções e células tumorais.
Enviado por
Talisson BonfimDireitos autorais
© © All Rights Reserved
Levamos muito a sério os direitos de conteúdo. Se você suspeita que este conteúdo é seu, reivindique-o aqui.
Formatos disponíveis
Baixe no formato PDF, TXT ou leia on-line no Scribd